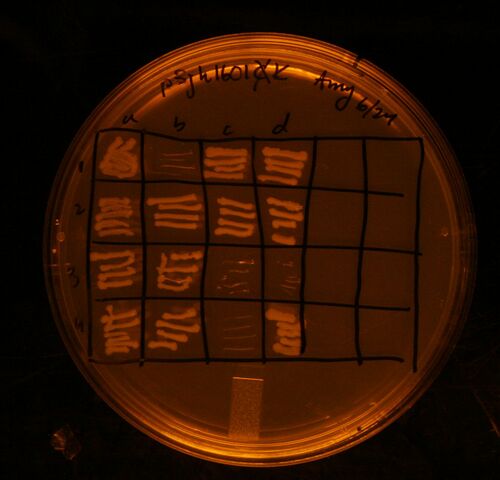
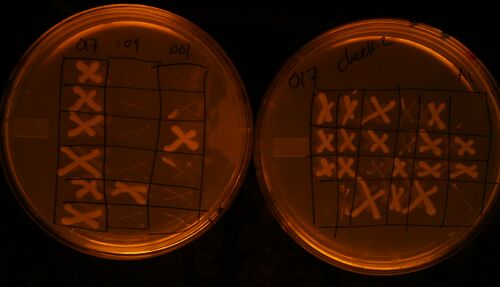
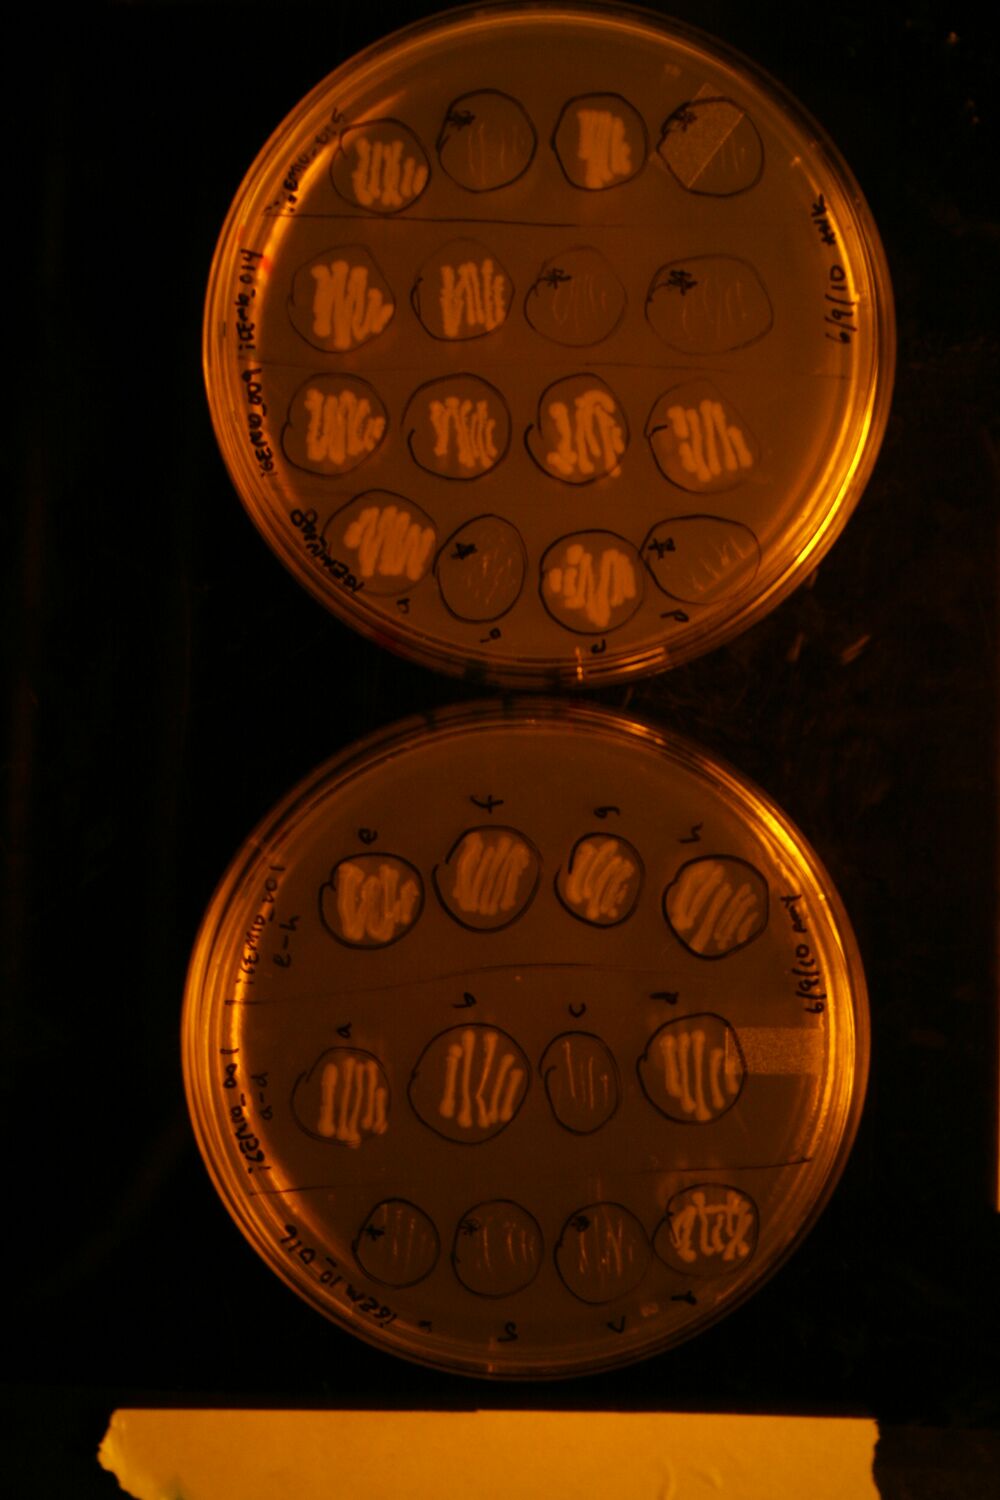

June entries
Return to Berk2010-Amy
Amy N. Kristofferson 12:56, 30 June 2010 (EDT)
Tn5 Transposase Assay
Testing to see whether the Transposase if functional.
Specifically, we varied atc concentration and the time allowed for transposase activity.
Inoculated cells drived from another colony off the iGEM10_020A plate, which didn't undergo co-transformation. We can use these for tests tomorrow.
- Added 10uL of 20% Arabinose (100X) to 1mL of lefty pir+ cells, transformed with iGEM10_020A (no co-transformation occured) at 1:30pm.
- At 2:30pm, will add varying amounts of atc to cells.
- 1uL of 1000X atc diluted 1:10
- 1uL of 1000x atc
- 3uL of 1000x atc
- At 3:30pm, will add 1uL of pBca9145-Bca1144DNA, and allow the transposase to do it's thing for varying amounts of time.
- 3:45pm (15min):Remove 250uL of lysate from each tube and spin down and zymo the supernatant.
- 4:00pm (30min): See above
- 4:15pm (45min): See above
- 4:30pm (1hour): See above (note: less than 250uL was left at this point)
Note: Talked to Terry, and he said one thing we definitely need to vary is the amount of time we give for Transposase expression.
Potential Problem: Used 2YT-Amp for the tubes colored with green sharpie. Hopefully this won't be a problem, since it's sorta the same thing as immediately plating on Amp.
Started rescue at 5:40pm.
Plated on Gen+Amp plates. Stored in incubator.
Problems with Step One of assembly of Jin's Parts
I meant to create the following parts yesterday:
| Lefty Digest | Righty Digest | Transform into | Plate on | Short Description | ' | Success? |
| 2114 | 2316 | R | CK | pCon.VacuoleBusterA | Transformed into Lefty instead. Lots of colonies. | |
| 2114 | 2275 | R | CK | pCon.VacuoleBusterB | Transformed into Lefty instead. Very few colonies. | |
| 2271 | 2071 | L | AC | Pbad.SelfLysisT | Transformed into Righty instead. Only 2 colonies. | |
| ig114 | 2071 | L | AC | Ptet.SelfLysisT | Transformed into Righty instead. Very few colonies. | |
...but I made a few mistakes yesterday.
Instead of performing the transformations as outlined above, I transformed 2271+2071 and ig114+2071 into righty and 2114+2316 and 2114+2275 into lefty. At least that's what my labelling on the plates suggests. Also, very few colonies grew on all but 2114+2316. Tomorrow, I'll redo everything using a one-pot reaction (see email from Tim).
2345 Redo
Picked 8 colonies, ran colony pcr, inoculated and plated on triple antibiotics.

Transduction: Genomic Miniprep, PCR att site, PCP transformation
Added 30uL of cells to 4mL of LB-K to grow up cells for PCP transformation. They're in the incubator.
Added 150uL of cells to 150uL of 50% glycerol to put in -80oC for later.
Performed genomic Miniprep. Added SDS at 10:50am. I accidently incubated in 37 instead of 55oC, but the tubes were clear even so. Plus I let it sit until 11:30am.
Animal Promoter
Jin gave me the following part: Bjh2093 in 1601AC-Righty that I'll have to add the EF1alpha promoter and Atub promoter ( Bjh2342 in 1601CA-Lefty). He also gave me Bjh2142 in 1601KC-Lefty, which is the CMV promoter.GFP.Term that we can use to compare the other promoters to. And I need to transfer everything into a high copy plasmid: 1256.
Amy N. Kristofferson 13:32, 29 June 2010 (EDT)
manual Assembly of Jin's Parts: Ligation of L/R digested parts
Made the following MasterMix x6 for four assembly's and 2345 gateway:
6.5uL ddH2O 1uL T4 DNA Ligase Buffer (small red or black-striped tubes) 1uL Vector digest 1uL Insert digest 0.5uL T4 DNA Ligase
Ligation started at 2:00pm.
Rescue started at 3:10pm.
Bjh2345 Gateway Redo
Started Eco/Bam Digest using 1uL of each enzyme and miniprep at 12:20pm.
Ligation started at 2:00pm.
Rescue started at 3:10pm.
Transduction Results
- No colonies grew on the MC1061 control plate.
- Lysate A: 7
- Lysate B: 6
- Lysate C: 12
- Lysate D: 5
I'm going to design primers so I can PCR off the genomic DNA to check the length of inserted DNA. Then I can perform a PCP transformation to remove the KanR cassette and then PCR off the genome again to check if if the size of the PCR product decreases by the length of the KanR cassette.
I can use Gabe's primers to run the PCR. They are in Josh's freezer in the green box. I just need to add 2uL of each oligo to 18uL of H2O and I'll be good to go.
| JH117F | ATCGCCTGTATGAACCTG | PCR of P21 att locus | 18 |
| JH117R | TAGAACTACCACCTGACC | PCR of P21 att locus | 18 |
I picked colonies from each plate to grow up and perform a genomic miniprep.
PCR: Bglbricking Ef1a and 30+31 PCR Redo
Expected lengths:
- Efla promoter: ~900bp
- 30+31 PCR off MC1061 genomic DNA: ~400bp
| Lane | Rxn | Tube | 2k55/45 | exp/phus | DMSO? | Correct? |
| 1 | ef1a | 5 | 55 | exp | yes | yes |
| 2 | ef1a | 6 | 55 | exp | yes | |
| 3 | ef1a | 7 | 55 | phus | yes | yes |
| 4 | ef1a | 8 | 55 | phus | yes | |
| 5 | DW KO 30+31 | 13 | 55 | exp | yes | no |
| 6 | DW KO 30+32 | 14 | 55 | exp | no | |
| 7 | DW KO 30+33 | 15 | 55 | phus | yes | no |
| 8 | DW KO 30+34 | 16 | 55 | phus | no | |
NOTE: The gel was super slanted. All those PCRs are probably the same length.
| Lane | Rxn | Tube | 2k55/45 | exp/phus | DMSO? | Correct? |
| 1 | ef1a | 1 | 45 | exp | yes | ok |
| 2 | ef1a | 2 | 45 | exp | ok | |
| 3 | ef1a | 3 | 45 | phus | yes | ok |
| 4 | ef1a | 4 | 45 | phus | ok | |
| 5 | DW KO 30+31 | 9 | 45 | exp | yes | no |
| 6 | DW KO 30+32 | 10 | 45 | exp | no | |
| 7 | DW KO 30+33 | 11 | 45 | phus | yes | ok |
| 8 | DW KO 30+34 | 12 | 45 | phus | ok | |
Since this PCR got slightly messed up, and the last two reactions seemed to work the best, I'll do them again.
What I kept:
- Ef1a: tube 5 rxn is stored as Ef1a PCR. I also held onto tubes 6-8 in their original PCR tubes. They're in my working box.
- 30+31: tube 7 and 8 are stored in their original PCR tubes in my working box. I'll probably redo them.
iGEM10_020: Picking colonies after Eco/Bam Transfer
Yesterday: Transfered 2 minipreps (iGEM10_020A and B) from Gibson Assembly vector (color=AC) to PMLL5CK R6K vector, transformed lefty pir+ cells with product, and plated on CK.
Today: Xed out green colonies, picked 8 colonies from A and B, inoculated them and plated on triple antibiotics to check for co-transformation.
Amy N. Kristofferson 14:37, 28 June 2010 (EDT)
Transposase Assay Plan
- Eco/Bam transfer into R6K plasmid (one of the PMLL plasmids)
- Transform into pir+ strain (Lefty)
- Grow up cells
- Add arabinose (100x stock solution) to allow for Transposase expression. Put in shaker for 1 hour.
- Add atc (1000x stock solution) to allow for self-lysis. Put in shaker for 1 hour.
- Add DNA (pUC-AmpR). NOTE: Don't know how much time Transposases will need. Take samples at different intervals?
Eco/Bam Transfer
Digested two minipreps of iGEM10_020 (A+B) with Eco/Bam. Zymo'd the digestion reactions (forgot to dry... hopefully this won't decrease efficiency too drastically) and started a ligation reaction at 3:00pm. Started rescue at 4:20pm. Plated on CK plate and put it in the incubator. Zymo'd digests are in my working box.
Transduction
Check cells grown on Kan plates. All plates were covered in a lawn of bacteria, which I didn't expect since transduction is supposed to be a very rare event. Good thing I ran a control where I plated the WT MC1061 cells on a Kan plate. Nothing should have grown, but instead the plate was covered in a lawn of bacteria. Most likely, my cells were contaminated because I had been growing them up over the course of the week in LB.
Yesterday I inoculated a fresh colony from Josh's plate in LB. Today I'll expose the cells to the lysate again.
Mixed MC1061 cells with lysate at 4:43pm. NOTE: when I spun down the MC1061 cells, the pellet seemed oddly discolored. Hopefully they aren't contaminated.
Added the 2YT-citrate at around 5:15pm.
Plated on Kan plates and put them in the incubator.
DW KO
Only one of the 24 samples I selected grew on the Kan plate, so the PCP flp was very successful. I chose one batch of cells from each strain (MC1061 iBgl9053 and iBgl9061) and added 150uL of those cells to 150uL of 50% glycerol and put them in the -80oC freezer in positions B1 and B2.
Manual Assembly of Jin's Parts: First Round
| Lefty Digest | Righty Digest | Transform into | Plate on | Short Description |
| 2114 | 2316 | R | CK | pCon.VacuoleBusterA |
| 2114 | 2275 | R | CK | pCon.VacuoleBusterB |
| 2271 | 2071 | L | AC | Pbad.SelfLysisT |
| ig114 | 2071 | L | AC | Ptet.SelfLysisT |
Made 5x the recipes listed below and added 4uL of Miniprepped DNA to 7uL of either Lefty or Righty MasterMix.
Lefty MasterMix (for 4uL miniprep DNA)
4uL water 1uL of NEB2 1uL XhoI 1uL BamH1
Righty MasterMix (for 4uL miniprep DNA)
4uL water 1uL of NEB2 1uL XhoI 1uL BglII
Incubate for 1 hour at 37deg C.
Started Digest at 3:42pm. Zymo'd digests and stored them in my Working Box in the freezer.
Amy N. Kristofferson 13:22, 25 June 2010 (EDT)
Self-Lysis Device
Inoculated 10uL of cel.ls from the No ATC batch of Self-Lysis Device cells in 2mL of LB-KA
Added atc at 4:25pm. They are upstairs in the shaker. I added 20uL of 1000x atc stock (2ug/mL) to 2mL of cells, 1uL of 1000x atc (200ng/mL), and 0.1uL of 1000x atc (20ng/mL). According to the registered TetR promoter, 50ng/mL should be more than sufficient for expression.
At 5:40pm, none of the flasks look like its cells lysed. I'm going to sequence the TetR-SelfLysis Device with ca998 (named iGEM027 in the sequence log).
I checked again at 6:00pm and held the flasks up to the light instead of just looking straight at them and lysis was very noticable. The flask with 20uL of atc was the most translucent, but lysis had definitely also occured in the 2uL flask. On Monday, I'll perform the experiment in a TECAN plate so we can measure OD overtime to see how long it takes for lysis to occur.
Colony PCR of 2345 and 2271 Redo
| Lane | Part | Expected Length | Good? | Miniprep |
| 1 | Bjh2345 | 2880 | ||
| 2 | \" | |||
| 3 | \" | |||
| 4 | \" | |||
| 5 | \" | |||
| 6 | \" | |||
| 7 | \" | |||
| 8 | \" | |||
| 9 | Bjh2271 | 1214 | ok | Y |
| 10 | \" | |||
| 11 | \" | |||
| 12 | NOTHING (cut in half) | |||
| 13 | \" | Good | Y | |
| 14 | \" | |||
| 15 | \" | |||
| 16 | \" | |||
Note: I didn't load the last of the 8 samples of 2271 b/c the cap wasn't fully on in the PCR machine so there was very little sample left.
The results of 2345 were awful, so I'm going to start over and re-ligate the Eco/Bam digest to the corresponding vector and re-transform.
Also, none of the samples were co-transformed.
Payload Delivery: pBjh1601K Miniprep
Selected sample 1b, 3c, 3d, 4c to miniprep since they failed to grow on this Cam plate:
Analytical digest/map of pBjh1601 and Bjh2271 minipreps
Eco/Bam Digest started at 12:40pm.
| Lane | Part | Digest | Expected Lengths | Good? |
| 1 | 2271-1 | Eco/Bam | 2877, 1014 | Good |
| 2 | 2271-4 | \" | \" | Good |
| 3 | pB1601K-1b | \" | 2475, 802 | Good |
| 4 | pB1601K-3c | \" | Good | |
| 5 | pB1601K-3d | \" | Good | |
| 6 | pB1601K-4c | \" | Good | |
All the minipreps look good. I'll choose one of each: 2771_4 and 1601K_1b to keep.
DW KO: Flping out the KanR cassette
I realized what the problem was with my last two transformations: I didn't make the cells competent before I transformed them. So this time around I'll follow this protocol to make the cells competent. I inoculated 40uL of Gabe's cells that I grew up last night in 4 mL of LB-K. They're up in the warm room.
I followed the protocol in the link above and plated the cells on Amp. They're in the 30oC egg.
Transduction
Added P1 lysate to MC1061 cells. Put them in the incubator at 2:55pm. They'll be done at 3:25pm.
Added 2YT/Citrate to the cells and put them in the shaker at 3:38pm. They'll be done at 4:38pm.
Amy N. Kristofferson 13:18, 24 June 2010 (EDT)
Payload Delivery: Plating samples on Cam to make sure CmR was removed
I plated the cells that Tim miniprepped on Cam plates and they all grew up when they shouldn't have, so I trashed the minipreps. I selected 12 new colonies, inoculated them, and plated them on Cam. Tomorrow I'll miniprep the samples that were not able to grow up on Cam, meaning the EIPCR was successful.
Animal Promoter
I also designed the following oligos to Bglbrick the EF1alpha promoter:
| oligo | sequence | length | description |
| igemTen045 | ccatgGAATTCatgAGATCTGACTGCTGCTCCCTTTGTTCA | 41 | Forward Bglbricking of ef1a promoter (new and improved sequence) |
| igemTen046 | cgttaggatccAATGGAAACGTGTTGCTTGCCG | 33 | Reverse Bglbricking of ef1a promoter (new and improved sequence) |
Mapping part 2
Bjh1968
Even though the results look good, I'm going to do one more test to make sure I have the part in the correct vector. I'm going to do and EcoRI/BseRI digestion. NEB4 buffer is recommended by NEB's Double Digest site.
Here's what the results should look like:

Rest of the parts
- 2345: Redo w/ Eco/XhoI b/c two fragments generated by Eco/Bam are too similar in length
- 2271: Redo w/ Eco/Bam b/c the bands are really faint
- 2114: Redo w/ Eco/XhoI b/c the part is too small
- 2271a2: Trash. I think the column was empty.
| Lane | Part | Digest | Expected lengths | Good? |
| 1 | 2345a | Eco/XhoI | 3753, 1672 | BAD-only one band |
| 2 | 2345c | Eco/XhoI | 3753, 1673 | BAD-only one band |
| 3 | 2271d | Eco/Bam | 2877, 1014 | Looks ok, just very dilute |
| 4 | 2114a | Eco/XhoI | 1466, 1322 | Good |
| 5 | 2114c | Eco/XhoI | 1466, 1323 | BAD-only one band |
| 6 | T1 | Eco/BseRI | (see picture) | Good |
| 7 | T2 | Eco/BseRI | Good | |
| 8 | T9 | Eco/BseRI | Good | |
| 9 | T10 | Eco/BseRI | Good | |
| 10 | B2 | Eco/BseRI | BAD | |
| 11 | B3 | Eco/BseRI | ? | |
| 12 | B10 | Eco/BseRI | Good | |
| 13 | B11 | Eco/BseRI | Good | |
Final results:
- Minipreps to keep: 2114a, 1968T1,ig114a,2316a,2275a
- Pick new colonies for: 2345, 2271
Redo of 2345 and 2271
I picked 8 colonies of each, ran a 3kCOLPCR, inoculated them and plated on triple antibiotics.
Self-Lysis ATC test
ATC protocol
When using atc to turn on a TetR promoter, the standard method is to add 1uL of 1000x (200ug/mL) atc to every 1mL of cells. This makes the final concentration 200ng/mL.
Testing the ATC at different concentrations
Inoculated 5 samples of 20uL of saturated culture from two colonies in 2mL of LB-KA at 12:50pm. Hopefully they will be at mid-log by 2:50pm.
I checked the cells at 4:04pm and they are still not at mid-log.
At 5:10pm, the cells appear to be at mid-log. I took them out and set added 0,1.5,1,0.5,0.25uL of 1000x atc to the five samples from two colonies (10 flasks total). They were put back in the 37oC shaker at 5:20pm.
30+31 PCR Attempt #3
Since the last PCR redo failed do the messed up programming on the old PCR machines, I'm going to redo the experiment in exactly the same way, but this time I'll used the correct programs.
Amy N. Kristofferson 14:34, 23 June 2010 (EDT)
Eco/Bam Transfer of Jin's Parts
None of the colonies were co-transfromed. And here's my interpretation of the Colony PCR results:
| Lane | Part | Expected length (part length+200bp) | Good lanes | Miniprep |
| 1,3,5,7 | Bjh2345 | 2880 | All bad. | a,c |
| 9,11,13,15 | Bjh2271 | 1214 | 15 | d |
| 2,4,6,8 | Bjh2114 | 243 | 2,6 | a,c |
| 10,12,14,16 | ig114 | 1881 | 10,12 | a,b* |
| 17,19,21,23 | Bjh2316 | 3010 | 17,19 | a,b |
| 25,27,29,31 | Bjh2275 | 3579 | All bad. | |
| 18,20,22,24,26,28,30,32,33,35,37,39 | Bjh1968 top | 3110 | 18,20,24,26,28,32,33,35 | |
| 34,36,38,40-48 | bottom | 36,38,42, 44-47 | ||
Mapping Bjh1968 Eco/Bam Transfer to Same-color plasmid
Double Digest with EcoRI/SphI in NEB2. MasterMix (x9)
4uL ddH2O 4uL Miniprepped plasmid 1uL 10x NEB Buffer 2 0.5uL EcoRI 0.5uL SphI
Digest started at 3:37pm. Will be done at 4:07pm.

| Lane | version of Bjh1968 | Good? |
| 1 | T1 | |
| 2 | T2 | |
| 3 | T9 | |
| 4 | T10 | |
| 5 | B2 | BAD |
| 6 | B3 | |
| 7 | B10 | |
| 8 | B11 | |
Mapping of all other Eco/Bam Transfer Plasmids
4uL ddH2O 1uL 10x NEB Buffer 2 0.5uL EcoRI 0.5uL BamHI/XhoI 4uL Miniprepped plasmid
Used XhoI for Righty Methylated Parts (Bjh2316 and Bjh2275)
Digest started at 4:21pm. Will be done at 4:51pm.
| Mapping of Minipreps | ' | ' | ' | ' |
| Lane | Expected Length | Good? | ||
| 1 | 2345a | Eco/Bam | 2745, 2680 | possibly. Do Eco/XhoI |
| 2 | 2345c | Eco/Bam | possibly. Do Eco/XhoI | |
| 3 | 2271a1 | Eco/Bam | 2877, 1014 | BAD |
| 4 | 2271d | Eco/Bam | Ok. Map again? | |
| 5 | 2114a | Eco/Bam | 2745, 43 | Map w/ Eco/XhoI |
| 6 | 2114c | Eco/Bam | (part too small) | |
| 7 | ig114a | Eco/Bam | 2877, 1244 | Good |
| 8 | ig114b | Eco/Bam | Good | |
| 9 | 2316a | Eco/Xho | 4015, 1672 | Good |
| 10 | 2316b | Eco/Xho | Good | |
| 11 | 2275a | Eco/Xho | 4584, 1672 | Good |
| 12 | 2275b | Eco/Xho | Good | |
| 13 | 2271a2 | Eco/Bam | 2877, 1014 | BAD |
Animal Promoter
Tim miniprepped four of the inoculations I grew up yesterday.
Amy N. Kristofferson 16:43, 22 June 2010 (EDT)
Eco/Bam Transfer of Jin's Parts
Picked 4 colonies of these parts: Bjh2345, Bjh2271, Bjh2316, Bjh2275, and Bjh2114 and ran a colony PCR, inoculated them, and plated on triple antibiotics to check for co-transformation.
Note: I accidently dipped another colony into lane 4.
Colony PCR Results
| Lane | Part | Expected length (part length+200bp) | Good lanes | Miniprep |
| 1,3,5,7 | Bjh2345 | 2880 | All bad. | a,c |
| 9,11,13,15 | Bjh2271 | 1214 | 15 | d |
| 2,4,6,8 | Bjh2114 | 243 | 2,6 | a,c |
| 10,12,14,16 | ig114 | 1444 | 10,12 | a,b* |
| 17,19,21,23 | Bjh2316 | 3010 | 17,19 | a,b |
| 25,27,29,31 | Bjh2275 | 3579 | All bad. | |
| 18,20,22,24,26,28,30,32,33,35,37,39 | Bjh1968 top | 3110 | 18,20,24,26,28,32,33,35 | |
| 34,36,38,40-48 | bottom | 36,38,42, 44-47 | ||
Since I was transferring the part Bjh1968 from a CA vector to an AC vector, I have to screen even more colonies to make sure there's no parent vector bleedthrough, since I can't select against it. So I chose 12 colonies from the Bjh1968 top band plate and 12 colonies from the Bjh1968 bottom band plate and inoculated them and ran a colony pcr. Tomorrow, I will miniprep the colonies that looked good on the colony pcr and map them to distinguish between the CA and AC plasmids.
I will digest the minipreps with EcoR1/SphI and expect the following results:

Animal Promoter: Inoculated colonies of jh1061CK with CmR removed
Colonies were inoculated in LB-Kan and placed upstairs in the shaker.
DW KO: Flping out KanR Marker take 2
Transformed 2 of Gab's strains with PCP plasmid, plated on ampicillin and put the plates in the 30oC egg.
Amy N. Kristofferson 13:29, 21 June 2010 (EDT)
Self-lysis Test
The colonies grew up well. I inoculated four of them today so I can hopefully test the self-lysis device with varying concentrations of NEW atc tomorrow.
D/W KO: Flping out the KanR cassette
No colonies grew on the Amp plate, meaning none were transformed with the PCP20 plasmid. I talked to Tim, and I think it's because I diluted a solution of PCP20 plasmid that had already been diluted. I'll inoculate more of Gab's cells today and redo the transformation tomorrow.
Transduction
I inoculated so MC1061 WT cells, so I can expose them to the P1 lysate tomorrow.
Eco/Bam Transfer of Jin's parts
Set up digest:
- Set up the digest mastermix:
For BBb transfers: 7.5uL ddH2O 1 uL NEB2+ATP Buffer 0.5uL EcoRI 0.5uL BamHI (0.5uL XhoI in Bjh1968 tube... see below) 1uL miniprepped plasmid (3uL for Bjh1968 b/c I'll have to gel purify it)
Started the digest at 2:20pm. We already have an Eco/Bam digest of ig114 and Bjh2017 is already in the correct vector, so I'm only digesting Bjh2345, Bjh2271, Bjh1968, Bjh2316, Bjh2275, and Bjh2114.
- Zymo'd all digests except Bjh1968. Products stored in my working box.
- Gel-purified Bjh1968. I cut out the two bands that seemed to be between 3000 and 2000bp (Including the XhoI fragment shouldn't harm anything)
I'm moving Bjh1968 from a CA vector to an AC vector, so I need to gel purify the digest so that no parent vector, closed CA vector, or CA-AC vector is cotransformed, since there's no way to select against it. However, the two fragments will be very hard to resolve since they're both around 3000bp, so at 3:04pm I added 0.5uL of XhoI to the digest tube so I can chop up the vector backbone. Now I should expect the following band sizes:
3196 (vector backbone that wasn't cut by XhoI) 2915 (the part I want) 2195 (XhoI cut backbone) 1001 (XhoI cut backbone)
- Ligation
6.5uL ddH2O 1uL T4 DNA Ligase Buffer (small red or black-striped tubes) 1uL Vector digest 1uL Insert digest 0.5uL T4 DNA Ligase
- Transformed lefty and right pir+ cells with the correct vectors and plated on the corresponding antibiotics.
| Part | Color |
| Bjh2345 | AC |
| Bjh2271 | AK |
| Bjh1968 | AC |
| Bjh2316 | AK |
| Bjh2275 | AK |
| Bjh2114 | CA |
| ig114 | AK |
Mapping of 30+31 Redo PCR products
Lanes 1-4 are 4-8 of the following table:
| Lane | 1k45/55 | Exp/Phus | DMSO |
| 1 | 55 | Exp | |
| 2 | 55 | Exp | yes |
| 3 | 55 | Phus | |
| 4 | 55 | Phus | yes |
| 5 | 45 | Exp | |
| 6 | 45 | Exp | yes |
| 7 | 45 | Phus | |
| 8 | 45 | Phus | yes |
Removal of CmR from pBjh1601CK-Bjh1925 for Animal Promoter
Transformed jtk049 cells and plated on Kan.
Amy N. Kristofferson 14:41, 18 June 2010 (EDT)
Self-Lysis Transformation
Transformed Righty pir+ cells with 6+24 (the Bjh2294 version of the self-lysis device in our assembly plasmid). Started Rescue at 12:57pm. Plated 70uL of the cells on a KA plate at 2:20pm.
PCR Results
- 30+31 primer pair PCR (3' KO) failed
- 28+29 primer pair PCR (5' KO) worked
- 32+33 primer pair PCR (removal of CmR from pBjh1601CK) worked.
30+31 Redo
| Lane | 1k45/55 | Exp/Phus | DMSO |
| 1 | 55 | Exp | |
| 2 | 55 | Exp | yes |
| 3 | 55 | Phus | |
| 4 | 55 | Phus | yes |
| 5 | 45 | Exp | |
| 6 | 45 | Exp | yes |
| 7 | 45 | Phus | |
| 8 | 45 | Phus | yes |
Results:
- 1-4 (1k55) failed. Most likely because the denaturation step was 5 min instead of 1 min long on those stupid, old tan PCR
machines.
- 5-8 are still chugging along. Apparently the program under the label "1K345" has an extension step the length of the "3K45" program. Great. I'll leave them in the PCR machine and check on them on Sunday.
32+33 EIPCR Re-ligation
Digest EiPCR product with SpeI:
- 8.5uL of eluted PCR product
- 1uL of NEB Buffer 4
- 0.5uL SpeI
Started Digest at 3:30pm. Zymo'd digest at 4:30pm.
D/W Knockout: Flping KanR cassette out of Gab's cells
Transformed Gab's cells (MC1061 Bgl9053 and Bgl9061) with the PCP20 plasmid. Plated on Amp and incubated the plates in the 30oC egg (PCP20 is temp-sensitive). These colonies will be ready to undergo the D/W knockout.
Amy N. Kristofferson 13:48, 17 June 2010 (EDT)
Transduction
Followed this protocol.
- Diluted 25uL of Will's MG1061 cells that had been transformed with pjh1233-Bwd0038 in 2.5mL of LB/Mg+Ca/Kan media. Put upstairs in the shaker at 11:34am. Will be done at 12:34pm.
- Added 100uL of P1 Virus at 12:48pm. Cells should be ready for the next step in 2 hours (around 2:48pm).
- Allowed cells 3 hours to lyse. Stored lysate (labeled p1 lysate A-D) in fridge in a stock box labeled "Amy's Fridge stock box"
D/W Knockout
Before performing the knockout/in, I'll have to Flp out the KanR cassette that it currently in the genome. To do this, I'll have to transform Gab's cells that I inoculated yesterday with the PCP20 plasmid by following this protocol: p20 Transformation. However, first I have to inoculate a few colonies. They're in the shaker upstairs. I'll do the transformation tomorrow.
Ran PCR off MC1061 genome ("631 genomic" in Tim's stock box) to make the homologous regions around the attB site for D/W KO. For this I used Expand Polymerase and a 2k55 program. PCR products are labeled 28+29 (5' homologous region) and 30+31 (3' region).
Animal Promoter
Ran an EIPCR off pBjh1601CK-Bjh1925 to remove CmR for the animal promoter stuff. Used Phusion polymerase and a a 2K55 program. PCR product is labeled 32+33.
Amy N. Kristofferson 14:19, 16 June 2010 (EDT)
Animal Promoter continued
Designed oligos to remove the CmR from pBjh1601CK-Bjh1925: iGEMten32 and iGEMten33. See "choano promoters" email for more info.
Will's Gateway Project
Talked to Gabe and received streaked plates of MC1061_iBgl9061 and MC1061_iBgl9053, which contain genomes that have had Cre Recombinase and FRT flanked KanR cassettes integrated into the p21 integration site. They are currently in the incubator.
Plan of Action:
- Option 1: Use Gab's strain for gateway, since the p21 integration site has already been destroyed. Will have to flip out KanR cassette and possibly knock out Cre recombinase. Could use Datsenko-Wanner to knock-in the p21 integrase and KanR cassette while knocking out Cre recombinase. Try integration again with just KanR cassette to make sure there are no more functioning attB sites in the genome?
- Option 2: Work with Will's strain. Use p1 transduction to transfer the integrated p21 integrase and KanR cassette into a fresh Mc1061 stain (will be inserted through homologous recombination at untouched attB site)
Question: has Will put the integrase into the att site? Or just a KanR cassette? Meaning, are we just doing transduction to knockout the attB site or are we doing it to insert the integrase too? I just can't find a composite part with the integrase and kanR cassette...
- Option 3: Start with a fresh MC1061 strain and integrate the p21 integrase at an attB site. Flip out KanR cassette, and try integration again with just KanR cassette to make sure all attB sites have been destroyed.
Transduction
Inoculated four colonies from Will's pjh1233-Bwd0038 in MC1061 plate in LB/Kan media. Vials are upstairs in the warm room. Tomorrow, I will infect them and create the p1 lysate.
Inoculated four colonies of Josh's 6/13/10 plate of WT MC1061 in LB media. Vials are upstairs in the warm room. I will use this as the recipient strain.
Datsenko/Wanner Knock-in/out
Useful Restriction Sites for creating KO cassettes
mfeI tail: gcataCaattG
BglII + Multiple cloning site: TATGCagatctTTAggatccTTACATgaattc
BglII: gcataagatct
XhoI: gcatactcgag
attP21/integrated cre knockout
Flanking FRF-KanR-FRT cassette with attP21 regions of homology: Insert regions of homology into pBth7004 vector.
- Insert 5' end: Digest, Ligate, select blue colonies (avoid any red coloring since RFP should have been spliced out)
- Insert 3' end: Digest, Ligate, select white colonies (avoid blue since BFP should have been spliced out)
Practice with Tim's KO
BglII/XhoI Digest of 204+205 and 208+209 PCR products.
Bam/XhoI Digest of pBth7004 vector (will cut out RFP).
MfeI/BglII Digest of 202+203 and 285+284 PCR products.
Next Steps:
- Zymo the PCR digests
- Gel purify the vector digestion. Cut out middle band.
(Parent vector~3750bp, Vector w/o RFP~2850bp, RFP~900bp)
To do
To do today:
- Zymo/gel purify digests
To do tomorrow:
- Ligate digests and transform.
- Dilute and make p1 lysate
Amy N. Kristofferson 16:17, 15 June 2010 (EDT)
Continued construction of the Animal Promoter
Analytical Gel
Lane 1,3,5,7: Samples 1,2,3,4
Lane 2,4,6,8: Samples 9,10,11,12
Lane 9,11,13,15: Samples 5,6,7,8
Lane 10,12,14,16: Samples 13,14,15,16
The odd lanes all have bands at around 100bp, suggesting that DMSO should NOT be used in future PCR runs and that the oligos designed for the two versions equally suck, since the PCR products were around 100bp instead of the desired 1800bp.
I will try to change the composition of the part by pinpointing which region of the part actually contains the promoter through BLAST.
Redesign oligos
Analysis of the sequence we were trying to PCR proved that we needed to re-select the promoter region, since at the beginning it contained large stretches of C's and T's and at the ending it included a large chunk of the EF1a coding sequence.
Jin sent us a new sequence of the promoter region for EF1a as well as the sequence for another animal promoter: the region in the 5' UTR of myosin class II heavy chain. I should design oligos off of this. NOTE (6/24): I have since talked to Jin and he says that the the myosin promoter hasn't been tested yet, so we shouldn't use it.
Amy N. Kristofferson 14:20, 14 June 2010 (EDT)
Checking for Co-transformation and Miniprep of iGEM10_001,009,017
Over the weekend, Tim selected colonies, checked for cotransformation, and miniprepped iGEM10_001a-c, iGEM10_009a-c, and iGEM10_017a-d. Here are the cotransformation results (Note: the "a-d" labels don't correspond to the plate in any organized way).
Mapping of iGEM10_001,009,017
Followed this mapping protocol. Started at 11:20am.
Lanes 1-3: iGEM10_001a-c (expected bands: ~1350, ~2750)
Lanes 4-6: iGEM10_009a-c (expected bands: ~1850, ~2750)
Lanes 7-10: iGEM10_017a-d (expected bands: ~860, ~2650)
Analysis:
iGEM10_001 looks good.
iGEM10_009 seems to be missing the ~1850 band
iGEM10_017 seems to be missing the ~860 band.
Wait until PCR w/ Gibson oligos is done before analyzing furthur.
Making Animal Promoter (EF1a) Basic Part: iGEM10_021
Construction Files
Version 1
Basic Part creation of Animal Promoter EF1a_ver1
PCR igemTen011/igemTen012 on Topo 2.1_Ef1a (1801bp, EcoR1/BamHI)
Sub into pBjk2741 (EcoR1/BamHI , L)
Product is pBjk2741-iGEM10_021 {EF1a}
------
igemTen011 Forward biobricking of {ef1-a promoter region} deeper into part
ccatgGAATTCatgAGATCTAGCCAGCAATAACCGGGTCGGTTGTTGAT
igemTen012 Reverse biobricking of {ef1-a promoter region} deeper into part
cgttaggatccGGCCTCGCCGTAGCCGGCAA
Version 2
Basic Part creation of Animal Promoter EF1a_ver2
PCR igemTen013/JH304R on Topo2.1_Ef1a ( bp, EcoR1/BamHI)
Sub into pBjk2741 (EcoR1/BamH1 , L)
Product is
------
igemTen013 Forward biobricking of {ef1-a promoter region} overlap part and vector
ccatgGAATTCatgAGATCTtgcaggtaccggtAGCCAGC
JH304R
PCR
Tried Expand and Fusion, w/ and w/o DMSO, and using 2k55 and 2k45 PCR program for each version of the part's construction files.
Notes:
- Used Expand and Fusion mastermixes
- Added 1uL of each oligo
- Used 0.25uL of Jin's NK19EF template (176.7ng/uL) was used in each tube.
| Tube | version | 2k55/45 | phu/expand | DMSO |
| 1 | 1 | 55 | phu | |
| 2 | 1 | 55 | phu | yes |
| 3 | 1 | 55 | exp | |
| 4 | 1 | 55 | exp | yes |
| 5 | 1 | 45 | phu | |
| 6 | 1 | 45 | phu | yes |
| 7 | 1 | 45 | exp | |
| 8 | 1 | 45 | exp | yes |
| 9 | 2 | 55 | phu | |
| 10 | 2 | 55 | phu | yes |
| 11 | 2 | 55 | exp | |
| 12 | 2 | 55 | exp | yes |
| 13 | 2 | 45 | phu | |
| 14 | 2 | 45 | phu | yes |
| 15 | 2 | 45 | exp | |
| 16 | 2 | 45 | exp | yes |
Amy N. Kristofferson 13:16, 11 June 2010 (EDT)
iGEM10_001 and 009 plates
After overnight incubation, 11 colonies grew up on iGEM10_009, but there are no colonies on the iGEM10_001 plate.
iGEM10_001 Trouble-shooting
- I don't think anything could have gone wrong with digestion/ligation/rescue/etc. because I made sure not to take any short-cuts.
- Used wrong antibiotics? No.
- Cut out wrong bands from gel? Yes. In my rush to calculate expected lengths before the DNA diffused all over the place in the gel, I miscalculated the expected lengths. Also, 2 of the sequences for the assembly plasmids listed in the Parts Calculator were switched and I only just realized it. I'll redo these parts again, but re-running a gel with my zymo'd digest and cutting out the CORRECT bands.
Here are the lengths I want:
1L: ~2700 top band (2719,1270 L)
1R: ~1300 bottom band (1681,1287 S)
9L: ~1700 top band (1728,1196 L)
9R: ~1300 bottom band (1607,1296 S)
New (and CORRECT) analysis of the gel
Based on these calculations, the gels look great. All the bands are where they should be. The only downside is that there's a lot of parent vector in 1L and 9L. So here's what I'm going to do:
- Digest 1L and 9L again, using 1uL of each enzyme instead of 0.5uL.
- Gel Purify
- Ligate with the digests of 1R and 9R I made yesterday.
- Transform
Redo of iGEM10_001L and iGEM10_009L Digests
- Digested 9+8 (1L) and 7+11 (9L) with an amended version of the Lefty MasterMix, which included using 1uL of each enzyme instead of 0.5uL. I doubled the amount of MM and DNA used so that I can gel purify 10uL and keep 10uL of Zymo'd product in stock.
- Digest start: 11:47am. Digest end: 12:47pm
- See next section for info on the ligation and transformation.
Lane 1: iGEM10_001 digested with XhoI and BamHI
Lane 2: iGEM10_009 digested with XhoI and BamHI
I cut out the bottom band for 1L and the top band for 9R and performed a Zymo Gel Purification. The eluted DNA was used in the ligation and the extra is stored in the working box.
2nd step of Assembly for iGEM10_020: Creating iGEM10_017
Digest
Digested iGEM10_014c with Lefty MasterMix and iGEM10_015b with Righty MasterMix.
Start time: 12:07pm
End time: 1:07pm
Ligation and Transformation
Minor hiccup: added 2YT to bacteria before performing heat shock for 9L+R and 14+15, so I redid the the ligation using the stored gel purified/zymo'd digested DNA. I shortened the ligation time to 15min.
Rescue:
iGEM10_001 started @ 3:24pm
iGEM10_009 and 017 started @3:57pm
Transformed into jtk049, so these parts aren't methylated.
Amy N. Kristofferson 13:35, 10 June 2010 (EDT)
Cotransformation results for iGEM10_001,8,9,014-016
The following samples did NOT undergo cotransformation:
8b,d
14c,d
15b,d
16a-c
1c
Based on these results and the colony PCR map, I will choose the following sample to miniprep:
8b,d
14c,d
15b,d
16a,b
Only 1 of the 8 samples I picked from iGEM10_001 was not cotransformed, and that was the one sample that didn't show up on the colony pcr map. Thus, I will make the part over again by following this procedure:
- submit its parent parts for sequencing
- redo the digest reactions of the parent parts at 2x the volume.
- run half of that volume on a gel, and if it maps well, cut out and gel purify the part of the vector that will ultimately become part of iGEM10_001.
I will also follow this procedure for iGEM10_009, because all of its samples were co-transformed.
Miniprep of iGEM10_008b+d,014c+d,015b+d,016a,b
All samples were miniprepped and stored in the working box. Note: there may be a problem with 8d, since I accidently used N3 before P2.
iGEM10_001 and 009 Redo
Digest
Doubled the digest mixture (used 8uL of DNA and 12uL of Mastermix), so we'd have enough DNA to run a gel as well.
iGEM10_001: Lefty (BamH1/XhoI digest): 9+8 (taken from well) Righty (Bgl/XhoI digest): 7+23 (**taken from working box miniprep** This could be the reason why the part hasn't worked thus far- we took the DNA from the well that didn't map very well)
iGEM10_009: Lefty (BamH1/XhoI digest): 7+11 (taken from well) Righty (Bgl/XhoI digest): 8+21 (taken from well)
Digest started 11:32am, will be done at 12:32pm.
Zymo
Means of getting rid of restriction enzymes. Didn't heat kill because BamH1 isn't denatured by heat killing. Eluted with 20uL of H2O. Products are labeled 9L, 9R, 1L, 1R on top and have details of their digestion on the side.
Gel Purification
To get rid of parent vector and to select for the side of the vector we want, I cut out the bottom band from the first three lanes and the top band of the last lane.

Lane 1: 1L (desired length: about 1100)
2: 1R (~1300)
3: 9L (~1200)
4: 9R (~1500)
Desired lengths based off of part calculator sequences and the lengths of the digested pieces that would ultimately be included in the iGEM10_001 or 009 composite part after ligation and appropriate antibiotics selection.
I combined the 1L with the 1R and the 9L with the 9R gel fragments and performed a Zymo Gel Purification, eluting with 17uL of water for each.
Ligation
Followed this protocol with the following amendments:
Mastermix
- 6.5uL ddH2O
- 1uL T4 DNA Ligase Buffer (black-striped tubes)
- 0.5uL T4 DNA Ligase
DNA
- 6uL of L+R gel purified DNA
Added DNA to MM at 3:54pm. The ligation will be done at 4:24pm.
Transformation
Transformed jtk049 cells and plated iGEM10_001 on CK and iGEM10_009 on AC.
Amy N. Kristofferson 13:20, 9 June 2010 (EDT)
Co-tranformation plate results for iGEM10_001-003
We plated the colonies we had picked to select for those containing iGEM10_001-003 on A,K and C in order to check for co-tranformation. Here are the results:
iGEM10_001a-d, iGEM10_002a-c, and iGEM10_003a were co-transformed.
Picking new iGEM10_001 colonies for colony PCR
Since iGEM10_001 didn't work at all (all colonies cotransformed), I picked 8 new colonies to perform colony pcr, inoculate and streak on triple antibiotic plates to check for cotransformation. Plates are in the incubator. Inoculations of colonies are upstairs in the warm room.
Miniprep of iGEM10_002d and iGEM10_003b,d
Miniprepped iGEM10_002d and iGEM10_003b,d to extract the plasmids. These colonies were not co-transformed, and 2d as welll as 3b looked successful on the colony pcr map. 3d didn't look as good on the map, but I miniprepped it anyway.
Colony PCR for iGEM10_001,8,9,014-016
I also performed the three steps outlines about for iGEM10_001,8,9,014-016. The plates and inoculations are stored in the same locations.
Here are the gel results:
Lane 1,3,5,7: iGEM10_008a-d Expected size: 1250
Lane 2,4,6,8: iGEM10_014a-d Expected size: 1660
Lane 9,11,13,15: iGEM10_009a-d Expected size: 480
Lane 10,12,14,16: iGEM10_015a-d Expected size: 280
Lane 17,19,21,23,25,27,29,31: iGEM10_001a-h Expected size: 1550
Lane 18,20,22,24: iGEM10_16a-d Expected size: 1050
Tomorrow, depending on how the cotranformation plates turn out, I will pick from following samples to miniprep (the starred samples look the best):
iGEM10_008a,d iGEM10_0014b*,c,d (b looks closer to 1660 than c) iGEM10_009b*,d (d may be cotransformed since two bands showed up) iGEM10_015b*, both a+d look ok too iGEM10_001b* (brightest band), d+e also look good iGEM10_016a-c look equally good.
Sequence Results from 7+10
7+10b and c sequenced perfectly, but 7c should be used since 7b showed signs of cotransformation (see sequence log for details)
Amy N. Kristofferson 13:18, 8 June 2010 (EDT)
Miniprep and Sequencing Submission for 7+10b,c
Miniprepped 7+10b and c. Put 8uL of each in Eppendorph tubes and submitted for sequencing. Skipped mapping step because part is only 100bp.
Colony PCR of iGEM10_001-003
Selected four colonies from each plate. Dipped the pipette tip in PCR tube with 40uL of MasterMix and a well containing 3mL of LB with the appropriate antibiotics, before spreading the pipette tip across a plate with all three antibiotics (to check for cotransformation).
iGEM10_001 (part 8 next to 23 in a CK vector): Expected band length: about 1500bp
iGEM10_002 (part 11 next to 6 in AC vector): Expected band length: about 550bp
iGEM10_003 (part 20 next to 5 in CK vector): Expected band length: about 1250bp

Colony PCR
Lane 1 iGEM10_003a (should be 1250bp)
Lane 2 iGEM10_003b (should be 1250bp)
Lane 3 iGEM10_003c (should be 1250bp)
4 iGEM10_003d (should be 1250bp)
5 iGEM10_001a (should be 1500bp)
6 iGEM10_001b (should be 1500bp)
7 iGEM10_001c (should be 1500bp)
8 iGEM10_001d (should be 1500bp)
9 iGEM10_002a (should be 550bp)
10 iGEM10_002b (should be 550bp)
11 iGEM10_002c (should be 550bp)
12 iGEM10_002d (should be 550bp)
We will choose the following samples to miniprep tomorrow:
iGEM10_001c,d
iGEM10_002c,d
iGEM10_003a,b
First step of Manual Assembly of iGEM10_013 and 20: Creating iGEM10_008-009 and 014-016
Digest
Added 4uL of DNA to each reaction (8uL for doubled reactions).
Digested 8+4, 7+11 (x2), 9+20 (x2) with Lefty MasterMix.
Digested 9+3, 8+1, 7+2, 7+19, 8+12 with Righty MasterMix.
Start time: 1:50pm Taken out of incubator at: ~2:50pm
Zymo
Eluted all samples with 10uL, except 7+11 and 9+20 (eluted with 20uL)
Ligate
Followed this protocol with the following amendments:
Set up 5 ligations (made MasterMix recipe x6)
Mastermix
- 6.5uL ddH2O
- 1uL T4 DNA Ligase Buffer (small red or black-striped tubes)
- 0.5uL T4 DNA Ligase
DNA
- 3uL Lefty vector
- 3uL Right vector
Started Ligation at 4:15pm
Amy N. Kristofferson 14:24, 7 June 2010 (EDT)
Colony PCR of 7+10
(vector=7, part=10)
Ran Col500PCR on four colonies picked off of 7+10 plate. Also innoculated each colony in 3mL of LB-KA. Put tubes in shaker upstairs.
Colony PCR of 7+10 (we forgot to do this last week).
Lane 1: ladder
Lane 2: sample a
Lane 3: b
Lane 4: c
Lane 5: d
Analysis: Part is about 100bp, so all samples look correct, because the PCR product should be around 300bp.
First step of Manual Assembly of iGEM10_007: Creating iGEM10_001-3
Digestion
Lefty MM added to 4uL of DNA: 9+8, 7+11, 9+20
Right MM added to 7+23, 8+6, 7+5
They should be done incubating at 3:48pm.
Lefty MasterMix (for 4uL miniprep DNA)
- 4uL water
- 1uL of NEB2
- 0.5uL XhoI
- 0.5uL BamH1
Righty MasterMix (for 4uL miniprep DNA)
- 4uL water
- 1uL of NEB2
- 0.5uL XhoI
- 0.5uL BglII
Zymo
Means of getting rid of restriction enzymes. Didn't heat kill because BamH1 isn't denatured by heat killing. Eluted with 10uL of H2O. Products are labeled 7+11 L, 9+8 L, 9+20 L.
Ligation:
Followed this protocol with the following amendments:
Mastermix
- 6.5uL ddH2O
- 1uL T4 DNA Ligase Buffer (small red or black-striped tubes)
- 0.5uL T4 DNA Ligase
DNA
- 3uL Lefty vector
- 3uL Right vector
Added DNA to MM at 5:17pm. Will incubate on bench until 5:37pm.
Transformation
We Transformed 9+20,7+5 (iGEM10_003) and 9+8, 7+23 (iGEM10_001) into the Lefty strain. And 7+11, 8+6 (iGEM10_002)into the Righty strain.